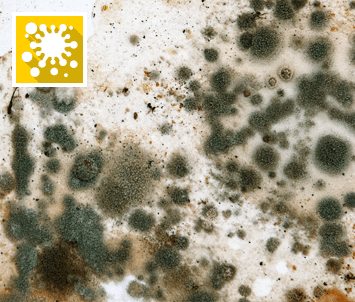

Damp, Condensation and Mould Training
Damp, condensation and mould are common challenges in housing, but with the right training, they can be effectively managed.
Our Damp, Condensation, and Mould Awareness online course provides housing professionals and anyone involved in providing housing with essential guidance on their legal obligations, as well as practical strategies to identify, prevent, and respond to damp and mould, ensuring safe, healthy homes for tenants.
-
Practical, real-world learning using housing industry case studies and scenarios
-
Flexible online access – start instantly and learn at your own pace, 24/7, all year round
-
Digital certificate upon completion to demonstrate knowledge and compliance
*Annual price per unit unless stated otherwise
£25.00
View our pricing options
About the Damp, Condensation and Mould Training Course
Damp, condensation and mould are persistent issues in the housing sector, posing serious health risks and legal challenges for housing providers. Our Damp, Mould and Condensation Awareness online training course is designed to help housing professionals understand their responsibilities, identify the causes, and take effective action to prevent and manage damp and mould problems in residential properties.
Aims of the Damp, Condensation and Mould course
By the end of this course you will be able to:
- Be aware of the prevalence and impact of damp, mould, and condensation in housing
- Understand the causes and indicators of damp, mould, and condensation
- Know your legal obligations for reporting and managing damp and mould
- Recognise the health risks associated with mould growth
- Have practical strategies for preventing and addressing damp, condensation, and mould in properties
Who is this online training course for?
This course is suitable for:
-
Housing officers and managers
-
Landlords and letting agents
-
Property maintenance teams
-
Social housing providers and contractors
-
Anyone working in or providing housing
Course Content
1Introduction to damp, condensation and mould
The course begins by introducing the fundamentals of damp, condensation and mould in housing. You’ll learn what they are, how common they are across UK homes, and the factors that increase the risk. The chapter also explains the impact on health (from respiratory and skin conditions to the risks for vulnerable groups), and highlights the property and legal implications of untreated issues.
Through real-world statistics, case studies, and interactive knowledge checks, you will learn about why addressing damp, condensation and mould is essential for protecting health, maintaining property integrity, ensuring compliance with housing regulations, and improving quality of life for tenants.
2Understanding the law
Chapter two covers the key legal standards and regulations related to damp, condensation and mould in housing. You’ll explore legislation including the Housing Health and Safety Rating System (HHSRS), Homes (Fitness for Human Habitation) Act 2018, Social Housing (Regulation) Act 2023, Part F Building Regulations, Housing Act 2004, Environmental Protection Act 1990, Landlord and Tenant Act 1985, Decent Homes Standard, and the upcoming Awaab’s Law.
The chapter explains the rights and responsibilities of social landlords, tenants, local authorities, contractors, and health and social care professionals. It also highlights how your role can help reduce the impact of damp, condensation and mould through:
-
Awareness and education: understanding causes and effects
-
Prompt action: addressing issues as soon as they arise
-
Collaboration: working with stakeholders to implement solutions
-
Advocacy: promoting best practices and policies to prevent damp and mould
By the end of this chapter, you should understand both the legal framework and practical steps you can take to ensure housing is safe, healthy, and compliant.
3Identifying damp
Chapter three explains damp – the presence of excess moisture in properties – and explains why it’s a common issue in homes across the UK. You’ll learn to recognise the typical areas affected and understand the risks associated with untreated damp, including potential damage to both property and health.
The chapter also highlights the main sources of damp and why early identification is important. By the end of this chapter, you’ll understand why addressing damp promptly is essential for maintaining a safe, healthy, and comfortable living environment.
4Understanding condensation
Next you’ll explore condensation, the most common form of dampness in homes. You’ll discover how everyday activities, indoor temperatures, and ventilation can contribute to condensation forming on cold surfaces.
The chapter explains where condensation typically occurs in properties, and looks at the potential risks it can create if left unaddressed. By the end, you’ll understand why managing condensation effectively is crucial for preventing damp, mould, and associated health or property issues.
5Tackling mould
This chapter is all about mould, a type of fungus that thrives in damp, humid conditions and can affect materials like wallpaper, wood, and carpet. You’ll learn to recognise the different types of mould and the common areas of a property where it can occur.
The chapter also explains the potential health risks associated with mould, including respiratory issues, allergies, and impacts on pre-existing conditions.
You’ll explore the main causes of mould and the importance of identifying it early, as well as strategies to manage and reduce its impact in your property.
By the end of this chapter, you’ll have a clear understanding of why mould is a serious issue and how addressing it promptly can help maintain a safe, healthy home environment.
6Taking action on damp, condensation and mould
Here, you’ll focus on what you can do when you encounter damp, condensation or mould in a property. You’ll explore a three-step approach to acting effectively: recognising the signs, reporting issues appropriately, and advising tenants or colleagues.
The chapter highlights the importance of timely and accurate action, including risk assessment and reporting responsibilities, and explains why damp, condensation and mould are not lifestyle issues. You’ll also learn best practice for communicating with tenants, ensuring they are informed and supported.
By the end of this chapter, you’ll understand how proactive action can help protect health, maintain property standards, and ensure compliance with housing responsibilities.
7 Tips for preventing damp, condensation and mould
The final chapter provides practical guidance on reducing the risk of damp, condensation and mould in your property. We provide strategies for both tenants and housing providers, including ways to manage moisture, ventilation, and property conditions effectively.
The chapter also explains how to take informed action when mould is present, and how to implement proactive measures to maintain a safe, healthy living environment.
By the end of this chapter, you’ll understand the key principles for preventing damp, condensation and mould, helping you protect health, maintain property integrity, and support tenants in achieving comfortable, compliant homes.
8 Assessment
You’ve reached the assessment section of the Damp, Condensation and Mould course. Here, you can test your knowledge with 10 questions covering the key topics from the course.
To successfully complete the assessment, you’ll need to answer 75% of questions correctly, and you can re-take the assessment if needed. Passing the assessment allows you to receive a digital certificate, demonstrating your understanding of damp, condensation and mould and your readiness to apply best practices in housing management.
You may also be interested in our Fire Safety, Health and Safety, and Social Care courses. These courses provide practical knowledge and guidance to help you maintain safe, compliant, and healthy environments, whether you work in housing, care, or property management. Explore these courses to expand your skills, protect tenants or residents, and ensure best practice across your organisation.
Ready-to-go online training
Our course modules are ready-to-go and you could be up and running in a matter of minutes. If you’re still unsure, learn more about the benefits of RealSense’s ready-to-go online training or simply ask us for a demo. We can help you get started and remember our support team are always on hand if you need them.
What is included?
Our course(s), designed by topic specialists, are simple and easy to use and can be completed at a learner’s own pace and at a time that suits them. The course(s) are available via our learning platform, Activbase, which provides 24/7 access to learning resources and digital training records. Certificates are available upon completion of courses.
When purchasing for larger groups of people, our simple onboarding process can help setup the Activbase platform to meet the specific needs of your organisation.
For further information, take a look at our Frequently Asked Questions, or if you would like a quote, a chat through your training requirements or just need some technical help then our team are here to help. Contact us today.
How is it delivered?
Modules are delivered via our online learning platform, Activbase or available in alternative formats for use on a customer’s own Learning Management System (LMS). Once payment has been received, you will be sent an email from RealSense confirming your purchase followed by a separate email from our Activbase Learning Platform with details on how to access your course(s). Access is available 24/7 for the duration of your license. Customers requiring a different course format e.g. SCORM for use on their own LMS, please contact us with your requirements.
Damp, Condensation and Mould Training
Upon successful completion, a certificate of achievement is available and or automatically added to a learner’s digital record.
Digital certificate(s) – print, download, store
A certificate includes the learner’s name, course title, completion score / result, completion date and any marks of approval, accreditation authorities, and or distribution partners. It can be downloaded, stored or printed.
Digital learning records
When using our platform Activbase, learning records are available 24/7 for review, tracking progress and access to certificates. Records contain details of sessions including progress, attempts and results. This and additional data such as associated CPD, standards and qualifications are logged and available for information insights and management reporting – a powerful resource for tracking compliance as well as monitoring learning pathways.
Please note: when accessing the course via standalone media or 3rd party systems, you will need to check those systems log learning activity appropriate to your training needs.

What they say…
Take a look at what organisations say about some of our online learning solutions
“Excellent Course well presented, plenty of content and easy to follow.”
Scottish Water
The RealSense team have the ability to really understand client needs and deliver exceptional results through their knowledge and passion for their craft. I cannot recommend them highly enough.”
M Group Services
“Realsense are extremely knowledgeable, authentic, flexible but most of all they listen to the specific requirements of their clients. Realsense pride themselves on knowing their clients and provide full customisation of courses. The menopause awareness programme designed for organisations to support their employees is a game-changer.”
Menopause 360
“The piece of work designed and developed by RealSense, tested and rolled out for HSBC was simply the best safety e-learning that the Bank had ever commissioned. We could not have done it without your expertise, drive and enthusiasm.”
HSBC UK
“RealSense proved to be helpful, responsive and supportive throughout… a very satisfactory innovative product design to meet customer need.”
Institute of Gas Engineers and Managers
“This e-learning training package is now even more flexible and easy-to-use, making it an excellent resource to assist employers in complying with fire safety legislation.”
Nottinghamshire Fire and Rescue Service
Product Specification
This module is designed to operate on industry standard multimedia PC compatible computers / laptops and or mobile devices with a suitable processor e.g. 2.0GHz Intel or AMD Processor, 4GB RAM or higher. A good reliable internet connection is required of at least 3Mb+/sec.
Web Browsers
Windows: Internet Explorer 11, Microsoft Edge (latest version), Google Chrome (latest version), Firefox (latest version)
Mac: Safari (latest version), Google Chrome (latest version), Firefox (latest version)
Mobile: Safari in Apple iOS 10 or later, Google Chrome in Apple iOS 10 or later, Google Chrome in Android OS 4.4 or later
Articulate Mobile Player
Articulate Mobile Player in Apple iOS 10 or later on iPad
Articulate Mobile Player in Android OS 4.4 or later (optimized for tablets)
Video-based Courses
OS: Windows 7+ | Browser: Up-to-date | Video: Up-to-date video drivers | Memory: 1Gb+ RAM | Download Speed: Broadband (3Mb+/sec)
Courses accompanied by the VideoTile logo with the IIRSM and or CPD logos are approved courses owned by VideoTile Learning Ltd and distributed under licence.
Browser compatibility
HTML5 is required as standard.
JavaScript must be enabled for published courses to work.
Font downloads must be enabled to see the correct fonts and characters.
When using Internet Explorer, turn off Compatibility View for sites where your courses are hosted.
Screen Readers
Windows: NVDA, JAWS 16 or later
Mac: VoiceOver
iPhone: VoiceOver
iPad: VoiceOver
Android: TalkBack
Accessibility Guidelines
Storyline 360 output supports Web Content Accessibility Guidelines (WCAG) 2.1 Level AA and Revised Section 508 standards. Click here for a Voluntary Product Accessibility Template® (VPAT®).
SCORM / AICC LMS
Our standard courses conform to SCORM / AICC (and TinCan) e-learning standards and have been successfully delivered on over 30 different learning management systems worldwide.
Activbase Online
Activbase is our own simple and easy to use learning platform for administrating, distributing and managing training. Our video based courses are streamed via our Activbase platform.
Other Devices
Most of our products are available on devices including Tablet, iPAD, smartphone or deliverable via media such as CD-ROM, USB memory stick and more. Let us know what you need.
Want to customise the ready-to-go training with your brand and learning materials?
Looking for a bespoke e-learning solution tailored to your learning and development needs?
Contact our team to day to find out more!
Frequently Asked Questions
Hidden by default
Your content goes here. Edit or remove this text inline or in the module Content settings. You can also style every aspect of this content in the module Design settings and even apply custom CSS to this text in the module Advanced settings.
Pre-sale - Have a question about price, discounts, customising, demos, access?
Q: How do I access the online learning course?
A: The course is accessed via our own Activbase learning platform, or can be made available as a SCORM object for you to upload to your own Learning Management System.
Q: What if I would like to add or change some of the content to make it more specific to my organisation?
A: We can swiftly tailor courses to suit your specific training needs. Please contact our team to discuss your requirements and request a quote.
Q: Is it possible to arrange a demo?
A: Yes, of course. If you would like to have a demo of a course or the Activbase Learning Platform then simply contact our team who will be able to arrange a demo for you.
Q: I represent an organisation with lots of employees we would like to train. Can your solution manage that? How much will it cost? Is there a discount when buying for a large workforce?
A: Our digital learning solutions are suitable for small, medium and large organisations. The solution is scalable so you can purchase for an individual or for a large organisation. We have an affordable pricing structure with discounts available for larger volumes. Simply let us know what courses you would like, how many employees you wish to train and we can tailor a package to suit your specific training needs. Simply ask us for a quote.
What is Activbase?
Activbase is a simple and easy to use Learning Management System (LMS) from RealSense that you can use to access your online learning courses. It provides hosting, administration, distribution and tracking of learning activities from a single cloud based platform. Find out more about the features and benefits of Activbase.
Using our courses - Technical query? Forgotten my password?
Q: I have a technical issue, what should I do?
A: That’s an easy one. Please contact us. You can get in touch via our online form, email our support team or call your account manager or our technical support team today.
Q: I have forgotten my password, what should I do?
A: If you have forgotten or lost your Activbase password, you can request a password reset through our learning platform, Activbase.
Records and certificates - Is the course accredited? What if i fail? Can I download my certificate?
Q: Is the course accredited?
Most of our courses are accredited by relevant authorities / approval bodies applicable to the course such as CPD, RoSPA or IIRSM. Please don’t hesitate to ask if you have any specific standard / approval requirements.
Q: Will I get a certificate?
All courses come with a certificate of achievement in recognition of completing the course successfully. A digital record is stored with each learner’s history and certificates are available for access and download.
Q: What if I fail my course?
If you do not achieve the pass rate for the course then you will be given the opportunity to review the training content and attempt the assessment again. With some of the video based courses, the course may be locked on a third failed attempt, subject to a review by your organisation administrator of a member of the RealSense support team.
I have another question, can you help?
If you cannot find the answer to your question here or in our detailed Frequently Asked Questions, then please don’t hesitate to contact our team. We are here to help answer your queries, help get you started and make sure you are maximising our digital learning solutions throughout.
Ready to get started?
With over a million courses delivered, we help learners fulfill compliance and develop their knowledge, skills and competence. Let us help you today.
Customise with your brand, policies and more
Looking for a bespoke learning solution?
View and discuss our flexible pricing options
Want to customise the ready-to-go training with your brand and learning materials?
Looking for a bespoke e-learning solution tailored to your learning and development needs?
Contact our team to day to find out more!